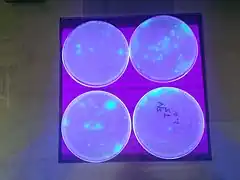
Description de cette image, également commentée ci-après

Pseudomonas fluorescens
| Domaine | Bacteria |
|---|---|
| Embranchement | Pseudomonadota |
| Classe | Gammaproteobacteria |
| Ordre | Pseudomonadales |
| Famille | Pseudomonadaceae |
| Genre | Pseudomonas |
Espèce

Pseudomonas fluorescens est un des sous-groupes bactériens appartenant au groupe des Pseudomonas fluorescens[3].
Les souches appartenant à ce sous-groupe sont à Gram négatif (KOH positif), oxydase positive, en forme de bâtonnet. Elle est mobile grâce à ses multiples flagelles. De plus, elle tient la deuxième partie de son nom (fluorescens) du fait qu'elle est fluorescente. Cette fluorescence est due à la production d'un pigment appelé pyoverdine[4]. Sa température de croissance optimale se situe entre 25 et 30 degrés Celsius.
Interactions avec les végétaux
De nombreuses bactéries appartenant à ce sous-groupe bactérien sont retrouvées au niveau de la zone de sol sous l'influence des racines de plantes (rhizosphère). Certaines souches appartenant à ce sous-groupe montrent même des effets bénéfiques pour la plante (suppressivité des sols)[5] et sont alors qualifiées de PGPR (Plant Growth-Promoting Rhizobacteria).
Contamination de produits alimentaires
La contamination de fromages par P. fluorescens est possible, la bactérie étant très présente dans l’environnement des vaches laitières (sol et plantes). Elle a pour conséquence de graves défauts sur les fromages : taches, défauts de goûts, défauts d’aspect des croûtes[6].
Ainsi, en , des consommateurs ont vu leur mozzarella (produite en Allemagne) virer au bleu à l'ouverture de leur sachet. Cette couleur a été attribuée à une contamination par P. fluorescens[7].
Liste de souches appartenant à ce sous-groupe bactérien
Selon NCBI (16 sept. 2011)[8] :
- Pseudomonas fluorescens A506
- Pseudomonas fluorescens BBc6R8
- Pseudomonas fluorescens HK44
- Pseudomonas fluorescens NZ007
- Pseudomonas fluorescens NZ011
- Pseudomonas fluorescens NZ052
- Pseudomonas fluorescens NZ17
- Pseudomonas fluorescens SS101
- Pseudomonas fluorescens WH6
Notes et références
- ↑ Catalogue of Life Checklist, consulté le 28 juillet 2014.
- ↑ (en) Roeland L Berendsen, Corné M J Pieterse, Peter A H M Bakker, « The rhizosphere microbiome and plant health », Trends Plant Sci, vol. 17, no 8, , p. 478-486 (DOI 10.1016/j.tplants.2012.04.001).
- ↑ (en) Magdalena Mulet, Jorge Lalucat et Elena García-Valdés, « DNA sequence-based analysis of the Pseudomonas species », Environmental Microbiology, vol. 12, , p. 1513-1530 (ISSN 1462-2920, DOI 10.1111/j.1462-2920.2010.02181.x, lire en ligne, consulté le )
- ↑ (en) Adela M. Luján, Pedro Gómez et Angus Buckling, « Siderophore cooperation of the bacterium Pseudomonas fluorescens in soil », Biology Letters, vol. 11, , p. 20140934 (ISSN 1744-9561 et 1744-957X, PMID 25694506, PMCID 4360104, DOI 10.1098/rsbl.2014.0934, lire en ligne, consulté le )
- ↑ Joyce E. Loper, Karl A. Hassan, Dmitri V. Mavrodi et Edward W. , II Davis, « Comparative Genomics of Plant-Associated Pseudomonas spp.: Insights into Diversity and Inheritance of Traits Involved in Multitrophic Interactions », PLoS Genet, vol. 8, , e1002784 (PMID 22792073, PMCID 3390384, DOI 10.1371/journal.pgen.1002784, lire en ligne, consulté le )
- ↑ Accidents de fromagerie — Pseudomona fluorescens.
- ↑ « Le Monde.fr, En Italie, la chasse aux "mozzarellas bleues". »
- ↑ NCBI, consulté le 16 sept. 2011.
Liens externes
- (en) Catalogue of Life : Pseudomonas fluorescens Migula, 1895 (consulté le )
- (fr + en) ITIS : Pseudomonas fluorescens (consulté le )
- (en) NCBI : Pseudomonas fluorescens (taxons inclus) (consulté le )
- Portail de la microbiologie